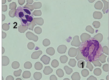

Vor mehr als zwei Jahrzehnten wurde bei Colliehunden erstmals ein Krankheitsbild beobachtet, bei dem es infolge der Behandlung mit dem Antiparasitikum Ivermectin zur Ausprägung schwerer neurologischer Symptome kam. Einige Tiere zeigten bereits nach Verabreichung subtherapeutischer Ivermectindosen Vomitus, Tremor, neurologische Bewegungsstörungen, Krämpfe sowie komatöse Zustände, sogar Todesfälle wurden beschrieben. Andere Tiere der Rasse tolerierten dagegen die Verabreichung wesentlich höherer (therapeutischer) Ivermectinkonzentrationen ohne neurologische Symptome zu entwickeln. Dieses Phänomen wurde als „Ivermectin-Unverträglichkeit des Collies“ bezeichnet. Mittlerweile sind zahlreiche Wirkstoffe bekannt, die bei verschiedenen Hunderassen und Mischlingen zur Ausbildung neurotoxischer Symptomatik mit dramatischen Krankheitsverläufen führen können. Dafür verantwortlich ist ein Gendefekt im MDR1- Gen der betroffenen Tiere. Besitzen Hunde dieses Defektgen, können bestimmte (lipophile) Substanzen ungehindert ins Gehirn eindringen, wo sie agonistisch an Gaba – Rezeptoren von Nervenzellen wirken. Schwere Vergiftungserscheinungen sind die Folge, die therapeutisch nicht mit einer spezifischen Therapie zu beeinflussen sind.
MDR1-Defekt – Die Mutation
Die Überempfindlichkeit gegenüber dem Antiparasitikum Ivermectin und weiteren Medikamenten ist durch einen Defekt im Multidrug-Resistance Transporter (MDR1) bedingt. Dieser Transporter fungiert als Effluxpumpe und sitzt u.a. in der Membran von Endothelzellen, die die Gehirnkapillaren auskleiden. Er übt im Gehirn eine Barrierefunktion aus (Blut/Hirnschranke), indem er Arzneistoffe und toxische Verbindungen in den Gehirnkapillaren zurückhält und sie wieder aktiv ins Blut transportiert. Damit wird ein Übertritt dieser Substanzen in das Nervengewebe verhindert. Das intakte MDR1- Protein wird auch als
P-Glycoprotein bezeichnet, besteht aus 1280 Aminosäuren und ist ein essentieller Bestandteil der Blut/Hirnschranke. Ist bei Hunden das Defektgen vorhanden, bricht die Synthese des MDR1-Proteins bereits nach ca. 10% des Leserahmens vorzeitig ab. Dem defekten MDR1-Gen fehlen vier Basenpaare, nach der Lokalisation des Defektes wird die Mutation als nt 230 (del4) bezeichnet.
MDR1-Defekt – Die Funktionen
Neben der Barrierefunktion im Gehirn, Hoden und der Plazenta übernimmt das MDR1-Protein in anderen Körperorganen Ausscheidungsfunktionen. So wird das MDR1-Protein in Leber, Niere und Darm exprimiert und ist an der Ausscheidung von Wirkstoffen (Leber, Niere) beteiligt. Ferner wirkt das MDR1- Protein im Darm als eine Absorptionsbarriere. Ist der MDR1- Transporter nicht intakt, verliert er einerseits seine Barrierefunktion im Gehirn/Hoden/ Plazenta, andererseits verändert sich die Pharmakokinetik für viele Substanzen durch verstärkte Absorption bzw. verzögerte Elimination. Eine fatale Kumulation von Wirkstoffen ist die Folge und der Organismus wird mit toxischen Substanzen überflutet. Zusätzlich übernimmt das MDR1- Protein auch Transportfunktionen und beeinflusst endokrine Regelkreise. So limitiert das intakte MDR1-Protein den Übertritt von NNR- Hormonen Cortisol und Corticosteron ins Gehirn. Ist diese „Transportkontrolle“ nicht mehr gewährleistet, kommt es zu einer down-Regulierung des feed-back- Mechanismus der Hypothalamus/ Hypophysenachse.
- Abb. 1: MDR1-Defekt beim Hund (Deutschland 2006 – 2009)
- Abb. 2: MDR1-Defekt beim Collie (Deutschland 2006 – 2009)
- Abb. 3: MDR1-Defekt nach Hunderassen (Deutschland 2006 – 2009)
Niedrige Basalcortisolkonzentrationen und ev. eine Suppression der Schilddrüsenhormone können die Folge sein. Bei betroffenen Tieren ist u. U. eine geringe Substitution von Schilddrüsenhormonen in Erwägung zu ziehen (in subtherapeutischer Dosis von ~1 mg/Tier). In einer prospektiven Studie aus den USA zeigten Tiere mit dem MDR1- Defektgen eine erhöhte Stressanfälligkeit (deutlich herabgesetzte Antwort der NNR nach Stimulation) im Vergleich zu MDR1-intakten Hunden und erholten sich langsamer von schweren Erkrankungen.
MDR1-Defekt – Die Rassen
Nachdem ursprünglich die Mutation nur bei Colliehunden beschrieben war, kennt man heute eine Vielzahl von Hunderassen und Mischlingen, bei denen der Defekt nachgewiesen wurde. Betroffene Rassen sind der Collie (Kurz-Langhaar), Australian Shepherd, English Shepherd, Sheltie, Bobtail, Border Collie, Weißer Schäferhund, Wäller, Longhaired Whippet und Silken Windhound. Eigene Untersuchungsergebnisse bei LABOKLIN in den Jahren von 2006 bis 2009 zeigten, dass ca. 57 % aller untersuchten Tiere frei waren von der MDR1-Mutation, ca. 32 % der untersuchten Tiere waren Träger und 11 % der Hunde waren homozygot betroffen.
MDR1-Defekt – beim Collie
Ca. 42 % aller eingesandten Proben stammten von Hunden der Rasse „Collie“. Unterteilt man die Colliehunde in verwandte Rassen, so wurden ca. 59 % zu „Collie unbestimmt“ gezählt, da hier keine detaillierte Rasseangabe von den einsendenden Praxen erfolgt war. Die zweitgrößte Probenanzahl stammte von Hunden der Rasse Border- Collie mit ca. 22 % aller Einsendungen. Danach folgten der Langhaar-Collie mit ca. 8 % der Proben, der Kurzhaar-Collie (7 %) und der Bearded Collie mit 3 % der Proben. Die Langhaarcollies stellten mit insgesamt ca. 33 % der getesteten Tiere die größte Zahl der homozygot betroffenen Hunde. Innerhalb dieser Gruppe nimmt der American Collie eine Sonderstellung ein, da er kein einziges „frei“– getestetes Tier aufwies, aber 60 % der Tiere homozygot betroffen waren und 40 % als Trägertiere identifiziert wurden. Die Gruppe „Collie-unbestimmt“ folgte mit ca. 26 % homozygot betroffenen Tieren, gefolgt von der Gruppe der Kurzhaarcollies mit ca. 17 % homozygot betroffenen Tieren. Bei den weiteren getesteten Rassen waren die homozygot betroffenen Hunde am häufigsten bei der Rasse Longhaired Whippet (12,5 %) zu finden, gefolgt von den Rassen Shetland Sheepdog (7,7 %) und Australian Shepherd (5,6 %). Bei den getesteten Bearded Collies war kein einziges homozygot betroffenes Tier dabei und nur 2,7 % wurden als Trägertiere identifiziert.
MDR1-Defekt – Die Arzneistoffe
Es sind zahlreiche Wirkstoffe bekannt, die die „Ivermectin-Unverträglichkeit“ bei Tieren mit homozygotem MDR1-Genotyp auslösen können. Bekannte Substanzen, die zu neurotoxischen Erscheinungen und Todesfällen führen bzw. für die eine Interaktion mit dem Multi-drug-transporter bei Hunden nachgewiesen wurde, sind Loperamid (Imodium®) und makrozyklische Laktone.
Zu den makrozyklischen Laktonen zählen zahlreiche Antiparasitaria aus der Stoffgruppe der Avermectine (Ivermectin, Doramectin, Moxidectin u.a.m.). Wenn Arzneimittel aus diesen Stoffgruppen bei MDR1-defekten Tieren eingesetzt werden, müssen sie ausdrücklich für die Anwendung am Hund zugelassen sein. Die Medikamente dürfen in keiner anderen als der angegebenen Applikationsform und Dosierung verabreicht werden (z.b. oral statt topisch). Für den Hund zugelassene Präparate sind z.B. Stronghold® , Advocate® und Milbemax®. Das Selamectinpräparat Stronghold® wurde bei MDR1 -homozygoten Collies als spot-on Formulierung getestet und es wurden keine Intoxikationsanzeichen beobachtet. Eine von den Herstellerangaben abweichende Dosierung bzw. eine andere Applikationsart als die zugelassene spot-on-Formulierung darf nicht gewählt werden. Auch bei dem Moxidectinpräparat Advocate® (enthält Moxidectin und Imidacloprid) wurden bei fachgerechter Anwendung entsprechend den Herstellerangaben (spot-on) keine klinischen Anzeichen einer Intoxikation beobachtet. Eine orale Applikationsform führte allerdings schon in geringerer Dosierung als der vom Hersteller empfohlenen bei topischer Anwendung, zu neurologischer Symptomatik und muss daher unterbleiben. Ein weiteres Präparat, das eingesetzt werden kann, aber bei MDR1-Defekt-homozygot betroffenen Hunden nur eine sehr geringe therapeutische Breite besitzt ist das Milbemycinoximpräparat Milbemax®. Neben Milbemycinoxim enthält Milbemax® Praziquantel und wird laut Herstellerangaben oral als Anthelmintikum und zur Herzwurmprophylaxe eingesetzt. In einer Studie in den USA zeigten Ivermectinsensitive Collies bei oraler Applikationsform bereits bei einer geringen Dosiserhöhung gegenüber den Herstellerangaben neurologische Symptome (vermehrte Salivation, Koordinationsstörungen etc.).
Für viele weitere Arzneigruppen wird eine Interaktion mit dem MDR1-Transporter in Zellkulturen bzw. Tiermodellen (knock-out Mäusen) angegeben bzw. vermutet. Dazu gehören diverse Zytostatika, Herzglykoside, Antiepileptika, Opioide, Steroidhormone, Antiemetika, Antiacida, Antiviral-wirksame Substanzen, Antibiotika und Antimykotika, immunsuppressiv wirkende Medikamente (Cyclosporine) und andere mehr (z.B. Acepromazin).
Die Washington State University empfiehlt bei der Anwendung von Acepromazin (in D z. B. Vetranquil®) und Butorphanol (in D z. B. Torbugesic®) bei Trägertieren eine Dosisreduzierung um 25% und bei homozygot betroffenen Tieren eine Dosisreduzierung um 30% bis 50%, da beide Wirkstoffe zu einer vertieften und verlängerten Sedation führen können. Für den Einsatz von Buprenorphine (in D z.B. Temgesic®) wird keine Dosierungsempfehlung für betroffene Hunde angegeben, obwohl eine Interaktion mit dem MDR1- Transporter vermutet wird.Weitere Hinweise auf Interaktionen des MDR1-Transporters mit Arzneistoffen finden sich auch in der Literatur (z.B. Plumb´s veterinary drug handbook 2008).
MDR1 – Der DNA-Test
Die Entdeckung der Mutation führte zur Entwicklung eines DNA-Tests, mit dessen Hilfe mit hoher Sicherheit Hunde identifiziert werden können, die eine genetisch bedingte „Ivermectin- Unverträglichkeit“ entwickelt haben. Für den DNA-Test wird zunächst aus einer Blutprobe die DNA des Tieres isoliert. Mittels der sogenannten Polymerase- Kettenreaktion wird dann das betroffene Gen millionenfach vervielfältigt, um es leichter analysieren zu können. Anschließend wird mittels Hilfe molekulargenetischer Methoden die Gensequenz hinsichtlich der Mutation nt 230(del4) untersucht. Somit kann die Mutation direkt nachgewiesen werden und vom MDR1-Defekt betroffene Hunde können sicher identifiziert werden. Der Gentest liefert als Ergebnis einen der drei möglichen Genotypen:
N/N: Der untersuchte Hund trägt das mutierte Gen nicht und kann die nt230 (del4) Mutation nicht auf seine Nachkommen übertragen.
N/MDR1: Der untersuchte Hund trägt ein mutiertes Gen und kann die nt230 (del4) Mutation mit einer Wahrscheinlichkeit von 50% auf seine Nachkommen übertragen. Bei Trägertieren können zum jetzigen Zeitpunkt Unverträglichkeitsreaktionen / Vergiftungssymptome nach Applikation von problematischen Wirkstoffen (s.o.) nicht sicher ausgeschlossen werden.
MDR1/MDR1: Der untersuchte Hund ist reinerbig für die nt230 (del4) Mutation (auf beiden Chromosomen vorhanden) und überträgt die Mutation auf seine Nachkommen. Homozygot betroffene Hunde können nach Applikation von problematischen Wirkstoffen (s.o.) Vergiftungserscheinungen entwickeln. Der DNA-Test zum Nachweis des MDR1- Defektes bietet Tierärzten und Züchtern ein effizientes und äußerst sicheres Mittel zur Identifizierung Ivermectin-sensitiver Tiere. Der DNA-Test kann bereits von Geburt an betroffene Tiere sicher identifizieren, so dass eine Entscheidung für/gegen eine Therapie leichter getroffen werden kann. Ferner können sinnvolle Zuchtentscheidungen getroffen werden um den MDR1-Defekt mittelfristig aus der Zucht zu entfernen.
12 / 2009